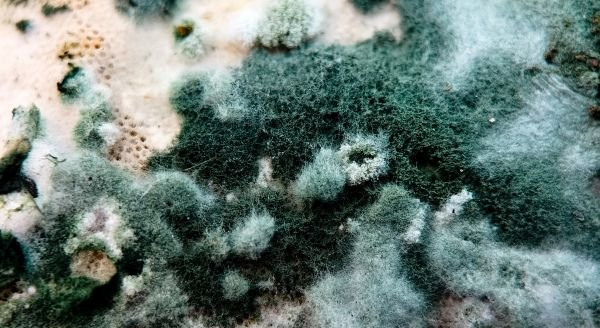

Mold Remediation, Removal & Testing in Fairview, TN
We provide professional remediation services for biohazards, crime scene, COVID-19, and many other services.
Contact UsFacts about Fairview, TN
 If you are dealing with mold do not wait! At T.A.C.T. of Middle Tennessee, we get mold under control with professional mold remediation for Fairview, TN, and the surrounding areas. Using industry-leading equipment and environmentally safe mold removal, we get rid of mold, while containing spores and toxins to prevent cross-contamination. With us, mold does not stand a chance! Contact us today to schedule a mold inspection or request emergency mold removal in Fairview, TN, or the surrounding areas.
If you are dealing with mold do not wait! At T.A.C.T. of Middle Tennessee, we get mold under control with professional mold remediation for Fairview, TN, and the surrounding areas. Using industry-leading equipment and environmentally safe mold removal, we get rid of mold, while containing spores and toxins to prevent cross-contamination. With us, mold does not stand a chance! Contact us today to schedule a mold inspection or request emergency mold removal in Fairview, TN, or the surrounding areas.
Mold Inspection & Mitigation in Fairview
Mold can hide in walls, under floors, or inside HVAC systems, silently affecting your health and property. That is why we provide expert mold inspection and mold mitigation to Fairview, TN, and beyond, that uncovers every hidden threat and stops it at its source.
We do not just remove visible mold. Our team identifies moisture problems, assess air quality, and implement targeted mold mitigation strategies that prevent future growth. Using industry-leading methods and proven technology, we ensure your home or business is always safe, healthy, and mold-free!
Mold Removal & Remediation in Fairview, TN
 Our mold removal and mold remediation process is built on years of experience, certified expertise, and industry-leading methods. All of our technicians are NORMI-certified (National Organization of Remediators and Mold Inspectors), ensuring every step of our mold remediation for Fairview, TN, and the surrounding areas, meets the highest standards for safety and effectiveness.
Our mold removal and mold remediation process is built on years of experience, certified expertise, and industry-leading methods. All of our technicians are NORMI-certified (National Organization of Remediators and Mold Inspectors), ensuring every step of our mold remediation for Fairview, TN, and the surrounding areas, meets the highest standards for safety and effectiveness.
From initial mold inspection to complete mold remediation, and professional suggestions for mold mitigation, we use advanced equipment and proven techniques to get the job done. Our mold removal process aims to:
- Identify hidden mold
- Eliminate spores
- Prevent future growth
- Restore properties
With us you are not just getting mold removal! You are getting a trusted, certified mold remediation that lasts.
Mold Testing in Fairview, Tennessee
Fairview, TN, is a picturesque community southwest of Nashville that provides a rare combination of natural beauty and small-town charm. Surrounded by rolling hills and the Bowie Nature Park, Fairview is perfect for outdoor enthusiasts, families, and anyone seeking a peaceful pace of life.
At T.A.C.T. of Middle Tennessee, we care about Fairview, TN and that is why we are here to provide professional mold testing for your home or business. Our mold inspection and mold testing services are the foundation of our mold removal, ensuring that every problem is identified, contained, and treated effectively. With our certified technicians and advanced equipment, we protect your property and your peace of mind. Contact us today to request professional mold testing in Fairview, TN, or the surrounding areas.
Serving Fairview, TN

Contact us here for
immediate response
-

We are certified, licensed, insured and bonded.
-

When you call T.A.C.T. you can be assured you are working with a well trained, compassionate and trustworthy company.
-

In many cases we can work with insurance companies to make this seem like a free service to our clients. It is one less worry and expense they have to think about during a tragic time.
